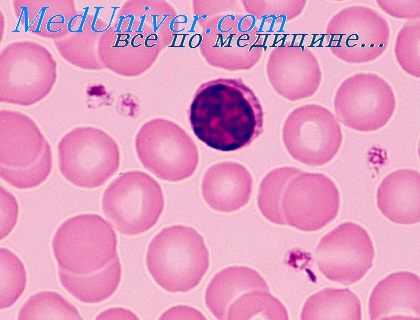
антителообразующие клетки

Взаимодействия антителообразующих клеток. Влияние клеток на синтез антител
Добавил пользователь Евгений Кузнецов Обновлено: 11.12.2025
Антитела (они же иммуноглобулины) — это специальные белки, которые вырабатывают клетки нашей иммунной системы для борьбы с «чужеродным вторжением» — проникновением в организм практически чего угодно, что наша иммунная система посчитает потенциально опасным. Это могут быть бактерии, вирусы, их токсины — так наш организм защищается от инфекции, или даже безобидная пыльца растений и лекарства — и в этом случае развивается аллергия.
Вещество, в ответ на которое начали вырабатываться антитела, называют антигеном. И да, антиген — это именно вещество, так как антитела вырабатываются не против вируса или бактерии «целиком», а против тех или иных конкретных вирусных или бактериальных белков. Например, если говорят об антителах против вируса гриппа, подразумевают антитела против двух белков из оболочки этого вируса — гемагглютинина и нейраминидазы. В случае SARS-CoV-2 речь чаще всего идет о шиповидном белке оболочки вируса (он же S-белок или спайк-белок).
Антитела обладают высокой специфичностью, то есть работают строго против определенного антигена или небольшой группы антигенов, очень сходных по своей структуре. Суть работы антител довольно простая — они химически связываются с антигеном и блокируют его взаимодействие с другими молекулами. Например, антитела против шиповидного белка оболочки коронавируса будут «прилипать» к этому белку, обволакивая вирусную частицу, — и такой вирус уже не сможет «прилипнуть» к клетке и проникнуть в нее. Кроме того, частицы с «налипшими» на них антителами гораздо «аппетитнее» выглядят для клеток нашей иммунной системы и будут быстрее поглощаться и перевариваться макрофагами — этот эффект называется «опсонизация».

Как организм понимает, какие антитела вырабатывать?
Выработка антител — довольно сложный и многостадийный процесс. Если очень коротко, то специальные клетки иммунной системы поглощают и переваривают потенциально опасную частицу (например, бактерию или вирус), буквально разбирают ее на кусочки. И затем показывают эти кусочки другим клеткам, которые подбирают подходящую структуру антитела так, чтобы это антитело могло химически связаться с одним из «кусочков» переваренной бактерии. Когда нужная структура найдена — запускается массовое производство антител. На этот процесс требуется немало времени, поэтому после первого контакта с антигеном накопление антител начинается примерно через 2 недели. Выработанные антитела циркулируют в крови около 4 недель, после чего разрушаются, при этом выработка новых антител может продолжаться.
Хорошая новость в том, что иммунная система умеет «запоминать» антигены, и при следующем контакте организму уже не нужно тратить 2 недели на поиск нужной структуры антитела — выработка начинается практически сразу. Именно так работает приобретенный иммунитет.
Иммунологическая память хранится разное время. Для некоторых инфекций, например для клещевого энцефалита, это 3–5 лет. Для других, например гепатита B или кори, — от десятков лет до пожизненной «гарантии». Именно от времени хранения иммунологической памяти, а не от текущей концентрации антител в крови зависит стойкость иммунитета и риск повторной инфекции.
Как антитела вырабатываются при вакцинации?
Для начала синтеза антител организму не обязательно сталкиваться с живой опасной бактерией или вирусом. Достаточно будет «убитого» или ослабленного микроба, кусочка его оболочки или даже отдельного белка — это тоже запустит иммунную реакцию и выработку антител. Эти антитела будут совершенно нормально работать и против живого опасного возбудителя инфекции. В этом и заключается смысл вакцинации — знакомим иммунную систему с ослабленным или убитым микробом, чтобы она научилась убивать живых и опасных.

Продолжительность вакцинного иммунитета тоже зависит от иммунологической памяти и может отличаться от естественного иммунитета, возникшего после болезни. Когда иммунитет угасает, нужно вакцинироваться снова. Для вакцин от разных инфекций есть свои графики повторной вакцинации, их частота зависит от времени хранения иммунологической памяти.
Вакцины, полученные по различной технологии, могут отличаться по времени действия вакцинного иммунитета. Обычно эти различия не слишком велики, так как продолжительность иммунитета в гораздо большей степени зависит от вида самого возбудителя, чем от конкретной вакцины.
На формирование защитного иммунитета также влияет состояние самого организма. Например, при тяжелых заболеваниях иммунной системы (наследственные иммунодефициты, злокачественные новообразования) иммунный ответ на вакцину может быть снижен или не формироваться вообще. Как показывает многолетний опыт использования разных вакцин, в случае ВИЧ-инфекции иммунный ответ на вакцины, как правило, ничем не отличается от иммунного ответа у ВИЧ-негативных людей. Поэтому графики вакцинации и дозы вакцины для ВИЧ-позитивных пациентов не будут иметь никаких особенностей.
по теме

Лечение
Безумно дорогое лекарство, которое спасет мир от пандемии
Некоторые лекарства, например глюкокортикоиды и иммунодепрессанты, могут подавлять формирование вакцинного иммунитета. В таких случаях тактику вакцинации нужно обсудить с врачом.
Для вакцин от новой коронавирусной инфекции время действия вакцинного иммунитета остается одним из главных вопросов. Предсказать продолжительность защиты той или иной вакцины очень трудно. Обычно это выясняют на практике, регистрируя частоту инфекций у привитых во время массовой вакцинации людей спустя разное количество времени, а также измеряя титр защитных антител.
Титр? Какой еще титр?
Как мы уже выяснили, антитела — это белки, которые циркулируют в крови. Для того чтобы обеспечивать эффективную защиту, эти белки должны быть в крови в определенной концентрации — ее и называют титром. Выражают титр в виде чисел, разделенных двоеточием, например 1:50 или 1:100 (читается как «один к пятидесяти» или «один к ста»).
Так как антитела — это сложные белки, определять их химическими методами крайне трудно. Поэтому для определения антител используют иммунологические реакции. Конкретных методов очень много, но в самом общем виде суть этих реакций очень простая. Мы берем раствор нужного антигена (например, того самого шиповидного белка коронавируса) и смешиваем его с сывороткой, в которой ищем антитела. Если антитела в сыворотке есть, то они связываются с антигеном и их соединение выпадает в виде осадка или раствор мутнеет. На практике проведение такой реакции выглядит сложнее, часто используют специальные гелевые среды и разные способы детектирования, но суть от этого не меняется.
Проблема в том, что такой подход отвечает нам только на вопрос, есть антитела в сыворотке или их нет, но ничего не говорит о количестве самих антител. Как в таком случае сравнить между собой две разные сыворотки? По количеству выпавшего осадка — не вариант, слишком большая погрешность. Но есть другой способ — можно разводить исследуемую сыворотку до тех пор, пока реакция (осадок) все еще будет обнаруживаться. И вот последнее, самое сильное разведение, при котором мы еще можем наблюдать реакцию сыворотки с раствором антигена, и называют титром этой сыворотки. То есть титр 1:50 говорит нам о том, что эту сыворотку можно развести в 50 раз и она еще будет давать реакцию с антигеном. Соответственно, чем больше вторая цифра в обозначении титра, тем выше концентрация антител в сыворотке.
Недостаток титра в том, что он указывает на относительное содержание антител. Если у нас есть две сыворотки с титрами 1:50 и 1:100, мы можем с уверенностью сказать, что во второй сыворотке антител в 2 раза больше, чем в первой. Но какая именно концентрация антител в каждой из этих сывороток, мы не знаем. На практике это часто бывает и не нужно: нам достаточно знать, с каким титром антител человек еще защищен от инфекции, а с каким — уже нет. Это легко выяснить, измеряя титр антител у вакцинированных людей, которые все же заразились.
В результатах лабораторных анализов обычно указывают концентрацию антител в международных единицах (МЕ) или относительных единицах (ОЕ). Результаты, полученные в МЕ, можно сравнивать между собой — значение не будет зависеть от лаборатории, тест-системы и условий анализа (для коронавируса таких пока нет). Результаты, выраженные в ОЕ, можно сравнивать между собой только для тестов одной марки, при этом сама лаборатория и время анализа роли не играют, то есть можно отслеживать динамику изменения уровня антител у одного человека.
Чтобы понять, нужна ли вакцина и подействовала ли она, достаточно измерить уровень антител? Какой нужен для ковида?
К сожалению, все немного сложнее. Антитела отвечают за гуморальный иммунитет — и это только лишь часть нашей иммунной системы. Помимо гуморального, есть еще клеточный иммунитет, работа которого не зависит от уровня антител. При защите от разных инфекций разные звенья иммунитета играют неодинаковые роли. В каких-то случаях ведущую роль имеет гуморальный иммунитет и антитела (например, в случае гепатита В, гриппа, столбняка и многих других инфекций). В других случаях — ведущая роль у клеточного иммунитета, например, при туберкулезе. По новой коронавирусной инфекции пока слишком мало данных, чтобы делать выводы о важности каждого из звеньев иммунитета и необходимом уровне антител. То есть даже если вы сделаете тест на антитела, эта информация практически ничего не даст по ряду причин.
Если вы еще не вакцинировались и тест на антитела будет положительным, что говорит о перенесенной инфекции в бессимптомной форме, это все равно не является противопоказанием к вакцинации. Мы не знаем, какова продолжительность естественного иммунитета, так что вакцина может продлить или усилить защиту.
Если вы делаете тест на антитела после вакцинации, сейчас нет надежных данных, с которыми можно было бы соотнести полученные результаты и сделать вывод о том, подействовала ли вакцина. Другими словами, пока никто не знает, сколько должно быть антител после вакцинации, чтобы гарантировать надежный уровень защиты. Плюс уровень антител ничего не говорит о состоянии клеточного иммунитета, а он тоже может быть очень важен для защиты.
Если вы наблюдаете за динамикой концентрации антител после вакцинации и видите ее снижение, это еще не говорит о снижении уровня защиты. Как мы выяснили выше, падение концентрации антител в крови с течением времени — это нормальное явление, а долговременную защиту обеспечивает иммунологическая память, которая с концентрацией антител не связана.
Не все антитела одинаково полезны
Для характеристики антител важно понимать их класс, тип и с каким антигеном они связываются.
Антитела бывают разных классов (A, M, G, E и др.). Основной класс защитных антител — G, в лабораторных исследованиях и тестах их обычно обозначают IgG. Наличие этих антител в крови говорит о наличие иммунитета после вакцинации или перенесенного заболевания. IgM — тоже защитные антитела, которые начинают вырабатываться первыми, раньше, чем IgG. Обычно IgM менее эффективны, чем IgG, и почти полностью исчезают к концу заболевания. Наличие этих антител обычно указывает на еще протекающее, или совсем недавно перенесенное заболевание, или на хроническую инфекцию. То есть, если нас интересует устойчивый иммунитет, в тестах ищем IgG.
Если антитело связывается с каким-то белком на поверхности вируса или бактерии, это далеко не всегда означает, что бактерия и вирус становятся после этого полностью безвредными. Например, вирус может использовать другой участок поверхностного белка для проникновения в клетку, не тот, с которым связалось антитело. Антитела, которые связываются с патогенами, но не подавляют их опасность, называют связывающими. Если же связывание антитела полностью «обезвреживает» микроб, «нейтрализует» его опасное влияние, такое антитело называют нейтрализующим. Связывающие антитела нельзя назвать полностью бесполезными — прикрепляясь к вирусу или бактерии, такие антитела делают их более заметными для клеток иммунной системы и ускоряют реакцию иммунитета. Но именно нейтрализующие антитела, которые могут самостоятельно обезвреживать опасные микробы, обеспечивают основную защиту, и именно их уровень важен при оценке вакцинного или естественного иммунитета. То есть в анализах нам нужно искать нейтрализующие IgG.
И, наконец, антиген. Как мы разбирали выше, антитела обладают очень высокой специфичностью и связываются только с определенными белками. Когда иммунная система, столкнувшись с инфекцией, подбирает нужное антитело, она чаще всего начинает синтезировать сразу несколько разных видов, нацеленных на разные белки возбудителя. Ведь клетки, синтезирующие антитела, получают для анализа разные кусочки полупереваренного микроба — и поверхностные, и внутренние белки — и для каждого из них ищут антитело. Для эффективной защиты важны именно те антитела, которые связываются с белками на поверхности вируса или бактерии. Ведь антитела — это крупные молекулы, которые не могут поникать внутрь вирусных частиц или бактерий, для них доступны только поверхностные белки. Именно поэтому защитный иммунитет в первую очередь обеспечивают антитела к поверхностным антигенам. Например, в случае коронавирусной инфекции вырабатывается как минимум 2 вида антител — к S-белку (который на поверхности вирусной частицы) и к N-белку (он же нуклеокапсидный белок, который находится внутри вирусной частицы). Так как до N-белка антитела добраться не могут, защиту будут обеспечивать именно антитела к S-белку. То есть, если вы все же хотите определить уровень защитных антител после прививки от ковида, нужно искать тест на нейтрализующие IgG к S-белку.
Взаимодействия антителообразующих клеток. Влияние клеток на синтез антител
Многочисленные исследования показали, что контактное торможение, возникающее в монослойных культурах, играет большую роль в регуляции роста клеток (Васильев, Маленков, 1968). В последние годы появились работы, в которых изучалось значение плотности культивируемых суспензий различных клеток для их роста.
В наших опытах было показано, что развитие первичного антителообразования в суспензии клеток селезенок мышей, культивируемых in vitro, сильно зависит от плотности культивируемых клеток. В определенных условиях увеличение плотности в 2 или 4 раза приводило к 10-кратному или даже 100-кратному уменьшению числа образующихся АОК. Подавление антителообразования в плотных культурах связано не с нарушением индукции АОК, а с последующим торможением пролиферации клеток этого клона.
На это указывает то, что торможение возникало и в тех случаях, когда плотность суспензии клеток увеличивали после окончания индукции антителообразования (через одни или трое суток после начала инкубации клеток с антигеном). Особо четко это выявилось при использовании суспензии клеток селезенок, которые предварительно культивировали с антигеном в течение трех суток и в которых происходило экспоненциальное нарастание числа АОК. После увеличения плотности таких культур нарастание числа АОК тормозилось очень быстро. Оно было четко выражено уже через 2—4 часа. Одновременно в клетках уплотненных культур резко тормозилось включение радиоактивных предшественников в ДНК, и особенно РНК. Включение метки в белки в первые 2—3 часа после уплотнения культур не снижалось или снижалось незначительно.
Чтобы выяснить, могут ли играть какую-либо роль локальные взаимотормозящие влияния в развитии иммунного процесса, было изучено влияние плотности на антителообразование в суспензии клеток селезенок, извлеченных из иммунизированных мышей. Оказалось, что в таких суспензиях нарастание числа АОК очень мало зависит от плотности культивируемых клеток.
Увеличение плотности, которое в суспензии клеток от неиммунизированного животного тормозило антителообразование в 10—100 раз, в суспензии клеток от иммунизированного животного тормозило его всего лишь в 1,5—2 раза или не тормозило совсем. Интересно отметить, что при увеличении плотности суспензии иммунных клеток суммарный синтез ДНК в суспензии тормозился очень сильно, не менее сильно, чем в суспензии клеток неиммунизированных животных.
Снятие взаимного торможения развивалось после иммунизации животного не сразу, для этого необходимо было не менее суток. Описываемый эффект был специфичным в отношении антигена. Так, введение мышам эритроцитов барана снимало тормозящее влияние плотности суспензии для нарастания числа АОК, образующих антитела против эритроцитов барана, но не АОК, образующих антитела против других антигенов (например, эритроцитов курицы).
Полученные нами факты позволяют сделать вывод, что подобно тому как малигнизация снимает контактное торможение, иммунизация специфически снимает взаимотормозящие влияния. Это позволяет предположить, что они играют определенную роль в регуляции антителообразования.
Информация на сайте подлежит консультации лечащим врачом и не заменяет очной консультации с ним.
См. подробнее в пользовательском соглашении.
Супрессорные Т- и В-лимфоциты. Фаза торможения антителообразования
Хотя впервые супрессоры были обнаружены сравнительно недавно (Gershon, Kondo, 1970), их изучение продвинулось далеко.
Оказалось, что Т-супрессорные клетки играют существенную роль в развитии как клеточного, так и гуморального иммунитета. В частности, велика их роль в развитии ряда форм толерантности (Gershon, Kondo, 1970; Weigle e. a., 1975), и особенно толерантности малой дозы (Kolsch е. а., 1975). С их функцией, по-видимому, связана аллотипическая супрессия.
Накопление Т-супрессоров с возрастом обусловливает падение иммунной реактивности животных при старении (Segre, Segre, 1976), а уменьшение их содержания приводит к резкому усилению склонности к образованию аутоантител (Krakaur е. а., 1976).
Параллельно с изучением роли Т-супрессоров были разработаны методы их фракционирования (Dutton, 1975; Gerber, Steinberg, 1975), была показана их гетерогенность (например, наличие среди них короткоживущих и долгоживущих форм), различие локализации Т-супрессоров и Т-хелперов в органах (Baker, 1975).
Удалось показать, что действие Т-супрессоров осуществляется путем выделения медиаторов.
Т-супрессоры можно подразделить на две группы: антигенснецифические и антигеннеспецифическис. Так, после иммунизации мышей комплексом МСАБ — ГАТ (метилированный сывороточный альбумин быка — L-глютаминовая кислота 60, L-алапин 30, L-тирозин 10) образуются Т-супрессоры, ингибирующие развитие антителообразования к этому антигену, но не к эритроцитам барана (Benacerraf e. a., 1975).

Специфические Т-супрессоры выявлялись и после иммунизации другими антигенами (например, ДНФ, эритроциты барана или гамма-глобулин человека) (Doyle e. a., 1976; Weigle e. a., 1975). Однако в других условиях иммунизация этими же или сходными антигенами приводит к появлению неспецифических Т-супрессоров. К такому же результату может приводить действие митогепов (например, конканавалина А) (Dutton, 1975).
Механизм действия Т-супрессоров неясен. Они могут действовать либо прямо на В-клетки, либо опосредованно, например уменьшая число способствующих антителообразованию Т-клеток. Сейчас нет сомнения в том, что Т-супрессоры участвуют в подавлении антителообразования при многих иммунологических процессах. Менее ясно, в какой степени с действием Т-супрессоров связан перелом кривой антителообразования после достижения пика этого процесса.
В пользу значения Т-супрессоров в развитии этого феномена свидетельствуют следующие данные: 1) иммунизация приводит к увеличению числа этих клеток (причем это увеличение иногда происходит даже тогда, когда иммунизация не индуцирует антителообразование); 2) это увеличение можно выявить уже через трое суток после введения антигена (Benacerraf е. а., 1975).
Инъекция антилимфоцитарной сыворотки мышам, иммунизированным полисахаридом SSS III, снимает на некоторое время перелом кривой антителообразования. Приводятся аргументы в пользу того, что это связано с инактивирующим действием антисыворотки на Т-супрессоры (Baker, 1975). Тем не менее нет оснований считать вопрос решенным. Нарастание числа Т-супрессоров только начинается, когда наступает фаза торможения антителообразования.
Введение мышам специфических Т-супрессоров одновременно с их иммунизацией хотя и подавляет образование IgG AOK в дальнейшем, но мало влияет на максимальное количество образовавшихся IgM AOK.
И, наконец, мы пытались в прямых опытах проверить, действительно ли во время фазы торможения в селезенке накапливаются супрессорные клетки, тормозящие пролиферацию АОК. С этой целью клетки селезенки, извлеченные в период наиболее выраженного торможения антителообразования (через шесть дней после иммунизации мышей эритроцитами барана), добавляли in vitro к суспензии клеток селезенки (извлеченной через два дня после иммунизации), в которой уже заканчивалась индукция антителообразования и протекала активная пролиферация АОК. Добавление таких клеток не только не тормозило нарастание числа АОК, но даже несколько его стимулировало (на 151%) (Гурвич и др., 1974).
Для выяснения реального механизма торможения необходимы дальнейшие исследования.
Антигены лимфоидных органов. Распределение антигенов для дифференцировки АОК
На примере введения белковых антигенов может быть легко продемонстрирована гетерогенность территории лимфоузлов как плацдарма, на котором лимфоциты распознают антигены и дифференцируются в антителопродуцирующие клетки. Локализация меченных радиоизотопами антигенов характерным образом изменяется в лимфоузлах по срокам после их введения. После подкожного введения антиген накапливается в регионарных лимфоузлах. Уже через 5 мин он обнаруживается в макрофагах, выстилающих синусы мозгового слоя лимфоузла, а через 24 часа перемещается в корковый слой.
Здесь антиген располагается в ретикулярных клетках, лежащих на границе тимусзависимых и тимуснезависимых зон, а именно вблизи вторичных фолликулов. Содержащие антиген дендритические ретикулярные клетки имеют длинные цитоплазматические отростки, на наружной клеточной мембране которых и располагаются молекулы антигена. Как антиген из макрофагов мозгового слоя передается в ретикулярные клетки коркового слоя, остается неизвестным.
К длинным отросткам ретикулярных клеток, содержащих антиген, подходят лимфоциты, а так как это происходит на границе тимусзависимых и тимуснезависимых областей, то естественно предположить, что распознавание антигена и кооперация Т- и В-клеток происходят именно в этих местах и что в ней участвуют дендритические клетки, репрезентирующие антиген, предварительно обработанный макрофагами. На периферии вторичных фолликулов, т. е. в непосредственном контакте с содержащими антиген ретикулярными клетками, происходит образование наиболее ранних в патогенетическом ряду клеток, синтезирующих антитела.

На 3-й день здесь обнаруживаются антителопродуцирующие плазмобласты, в которых синтезируются IgM-аптитела. Клональный характер развития этих клеток из родоначальных В-клеток предшественников твердо доказан. В случае тимусзависимых антигенов для начала пролиферации и дифференцировки этих клоногенных В-предшественников требуется их активация не только антигеном (через поверхностный рецептор в виде молекул встроенного в наружную клеточную мембрану иммуноглобулина), но и стимуляция со стороны активированной антигеном Т-клетки (Miller, 1974). Стимуляция осуществляется короткодистантным гуморальным фактором, который понижает порог чувствительности В-клетки к действию антигена.
Начавшая пролиферацию и дифференцировку В-клетка проделывает первые шесть мнтотических делений, находясь в корковом слое лимфоузла, затрачивая по 6—9 час на каждый митотический цикл. В результате образуется около 60 плазмобластов, продолжающих синтезировать IgM-аптитела сравнительно низкой авидности; интенсивность синтеза иммуноглобулинов в плазмобластах невелика. Следующие этапы своего развития потомки клоногенных клеток проделывают уже не в корковом, а в мозговом слое лимфоузлов.
Часть плазмобластов мигрирует при этом в мякотные шнуры и, продолжая размножаться на их территории, проделывает еще 2—4 деления, в результате которых образуется 250—1000 юных плазматических клеток, которые затем дифференцируются в уже неделящнеся зрелые плазматические клетки, срок жизни которых составляет около 48 час (Nossal, 1962). Синтез антител в юных, и особенно в зрелых плазматических клетках, происходит с гораздо большей интенсивностью, чем в плазмобластах, — около 107 молекул иммуноглобулина в час.
Иммунологическая специфичность этих секретируемых антител соответствует специфичности иммуноглобулиновых рецепторов, синтезируемых исходной В-клеткой (с интенсивностью 10 4 рецепторных молекул в час).
- Вернуться в оглавление раздела "Физиология человека."
Как клетки вырабатывают антитела: какие антитела продуцируют, что значит уровень антител

Анализы на антитела (иммуноглобулины, Ig) — важная часть диагностики различных инфекционных и аутоиммунных заболеваний. Вырабатываются эти белки иммунной системой и играют ключевую роль в борьбе с вирусами, бактериями, грибками. Какие антитела продуцируют клетки и за что отвечает каждый класс Ig, расскажет MedAboutMe.
Что такое антитела

Иммуноглобулины — ключевой компонент специфического иммунитета. Вырабатываются они в ответ на конкретный возбудитель и способны бороться именно с ним. Антитела синтезируются В-лимфоцитами при контакте с инфекцией. Кроме этого, Ig передаются от матери к ребенку и обеспечивают ему защиту на первые полгода жизни.
Существует несколько классов антител, основные из которых — IgA, IgM, IgG. Именно по соотношению разных классов иммуноглобулинов врач может оценить стадию болезни и ее течение. Определяются антитела методом иммуноферментного (ИФА) или иммунохемилюминесцентного (ИХЛА) анализа. Кровь сдается на конкретные виды антител, например, IgM и IgG к вирусу кори или вирусу SARS-CoV-2.
Кроме этого, антитела могут вырабатываться против клеток организма и в дальнейшем их атаковать — в этом случае они называются антителам, а у человека развивается аутоиммунное заболевание.
IgA — антитела, которые обнаруживаются преимущественно в секретах (на слизистых носа и горла, в кишечнике, в мочеполовых путях). Здесь этот класс иммуноглобулинов обеспечивает местную защиту, прежде всего против вирусов.
В меньшем количестве IgA присутствуют в крови. Вырабатываются они достаточно быстро и появляются уже в острой стадии болезни.
IgМ — главный маркер острого заболевания. Такие антитела продуцируются В-лимфоцитами на ранних стадиях болезни, обнаружить их в крови можно в среднем через 5 дней после развития инфекции.
IgM достаточно крупные по размеру, поэтому они не могут проходить через плацентарный барьер. Это объясняет, почему заражение некоторыми инфекциями, например, краснухой, во время беременности несет серьезную опасность для плода.
IgG начинают вырабатываться спустя 14-20 дней после начала инфекционного процесса. Их основная задача — не столько борьба с имеющейся болезнью, сколько защита организма в дальнейшем. Это антитела, отвечающие за иммунитет перед конкретной болезнью.
Синтез IgG — основная задача прививок. С вакциной человек получает ослабленный микроб или его фрагмент, иммунная система реагирует на это и вырабатывает антитела класса G, которые при последующем контакте с инфекцией не дают ей развиться.
Кроме этого, иммуноглобулины G мелкие и могут проникать через плацентарный барьер. А значит, обеспечивают защиту плода.
IgG к разным инфекциям остаются в организме на разное время. Так, антитела к кори и ветрянке могут циркулировать в крови пожизненно, а к сезонным респираторным вирусам — всего 1-3 года. Продолжительность жизни антител IgG к SARS-CoV-2 вообще зависит от индивидуальных особенностей пациентов. Так, в The Lancet Microbe было опубликовано исследование, которое показывает, что иммунитет от COVID-19 может не развиться вообще или же оставаться десятилетиями. Ученые наблюдали за 164 пациентами и получили следующие результаты:
Читайте также:
- Опухоли слезного мясца: признаки, гистология, лечение, прогноз
- Родственники больных шизофренией. Воздействие родственников на шизофрению
- Микрофлора полости рта при патологии. Микрофлора рта при заболеваниях.
- Клиника растяжения голеностопного сустава. Диагностика
- Двухфазный потенциал действия миокарда: деполяризация и реполяризация
